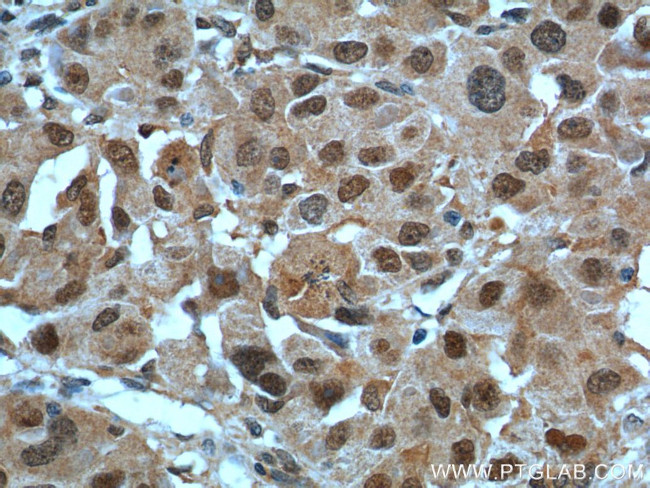
POLR1E Antibody in Immunohistochemistry (Paraffin) (IHC (P))

Search
Proteintech
POLR1E Polyclonal Antibody
{{$productOrderCtrl.translations['antibody.pdp.commerceCard.promotion.promotions']}}
{{$productOrderCtrl.translations['antibody.pdp.commerceCard.promotion.viewpromo']}}
{{$productOrderCtrl.translations['antibody.pdp.commerceCard.promotion.promocode']}}: {{promo.promoCode}} {{promo.promoTitle}} {{promo.promoDescription}}. {{$productOrderCtrl.translations['antibody.pdp.commerceCard.promotion.learnmore']}}
产品信息
16145-1-AP
种属反应
宿主/亚型
分类
类型
抗原
偶联物
形式
浓度
规格
纯化类型
保存液
内含物
保存条件
运输条件
产品详细信息
Immunogen sequence: AELFNMQPL FSDVSVESEL ALESQTKTYR EKMDSCIEAF GTTKQKRALN TRRMNRVGNE SLNRAVAKAA ETIIDTKGVT ALVSDAIHND LQDDSLYLPP CYDDAAKPED VYKFEDLLSP AEYEALQSPS EAFRNVTSEE ILKMIEENSH CTFVIEALKS LPSDVESRDR QARCIWFLDT LIKFRAHRVV KRKSALGPGV PHIINTKLLK HFTCLTYNNG RLRNLISDSM KAKITAYVII LALHIHDFQI DLTVLQRDLK LSEKRMMEIA KAMRLKISKR KVSVAAGSEE DHKLGTLSLP LPPAQTSDRL AKRRKIT (104-419 aa encoded by BC014331 )
靶标信息
DNA-dependent RNA polymerase catalyzes the transcription of DNA into RNA using the four ribonucleoside triphosphates as substrates. Component of RNA polymerase I which synthesizes ribosomal RNA precursors (PubMed:24207024). Appears to be involved in the formation of the initiation complex at the promoter by mediating the interaction between Pol I and UBTF/UBF (PubMed:24207024). [UniProt]
仅用于科研。不用于诊断过程。未经明确授权不得转售。
生物信息学
蛋白别名: DNA-directed RNA polymerase I subunit E; DNA-directed RNA polymerase I subunit RPA49; FLJ13390; FLJ13970; PAF53; polymerase (RNA) I associated factor 1; polymerase (RNA) I polypeptide E, 53kDa; polymerase (RNA) I subunit E; RNA polymerase I associated factor (Paf53); RNA polymerase I subunit A49; RNA polymerase I-associated factor 1; RNA polymerase I-associated factor 53; RP11-405L18.3; unnamed protein product
基因别名: 53kDa; A49; AU042259; D030019D19Rik; PAF53; POLR1E; PRAF1; RGD1565773; RPA49
UniProt ID: (Human) Q9GZS1, (Mouse) Q8K202
Entrez Gene ID: (Human) 64425, (Mouse) 64424, (Rat) 313245